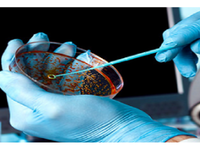
Ινστιτούτο Παστέρ: Ίσως και το φθινόπωρο...

Σύμφωνα με τον Παγκόσμιο Οργανισμό Υγείας
Τρία από τα εβδομήντα εμβόλια κατά του κορωνοϊού, που αναπτύσσονται σε όλον τον κόσμο, δοκιμάζονται σε ανθρώπους, σύμφωνα με τον Παγκόσμιο Οργανισμό Υγείας. Σύμφωνα με δημοσίευμα του Bloomberg, αυτό που έχει προχωρήσει περισσότερο στην κλινική διαδικασία είναι ένα πειραματικό εμβόλιο από την εταιρεία CanSino Biologics (Χονγκ Κονγκ) και το Ινστιτούτο Βιοτεχνολογίας του Πεκίνου, καθώς βρίσκεται ήδη στη Φάση 2.
Ακόμη δύο δοκιμάζονται σε ανθρώπους -πρόκειται για το εμβόλιο που αναπτύσσουν ξεχωριστά οι αμερικανικές φαρμακευτικές εταιρείες Moderna και Inovio, σύμφωνα με έγγραφο του Παγκόσμιου Οργανισμού Υγείας.
Η πρόοδος σημειώνεται με πρωτοφανή ταχύτητα στην ανάπτυξη εμβολίων, καθώς ο ιός φαίνεται απίθανο να εξαλειφθεί μόνο με τα περιοριστικά μέτρα. Η βιομηχανία φαρμάκων ελπίζει να συμπιέσει το χρόνο που χρειάζεται για να βγει ένα εμβόλιο στην αγορά μέσα στο επόμενο έτος.
Οι μεγάλες και οι μικρές εταιρείες του κλάδου κάνουν μεγάλες προσπάθειες για να αναπτύξουν ένα εμβόλιο, το οποίο θα αποτελέσει τον πιο αποτελεσματικό τρόπο για να περιοριστεί ο ιός.
Φαρμακευτικοί κολοσσοί όπως η Pfizer Inc. και η Sanofi έχουν υποψήφια εμβόλια σε προκλινικά στάδια, σύμφωνα με το έγγραφο του ΠΟΥ.
Η CanSino δήλωσε τον περασμένο μήνα ότι έλαβε την Κινεζική ρυθμιστική έγκριση για να ξεκινήσει ανθρώπινες δοκιμές του εμβολίου της.
Η Moderna που ποτέ δεν έβγαλε ένα προϊόν, έλαβε έγκριση από το ρυθμιστικό σώμα για να κινηθεί γρήγορα στις δοκιμές του ανθρώπου τον Μάρτιο, παρακάμπτοντας τα χρόνια δοκιμών σε ζώα που αποτελούν τον κανόνα στην ανάπτυξη εμβολίων.
Η Inovio ξεκίνησε τις ανθρώπινες δοκιμές της την περασμένη εβδομάδα.
Πηγή: protothema
Ακολουθήστε το thebest.gr στο Google News και μάθετε πρώτοι όλες τις ειδήσεις
Δείτε όλες τις τελευταίες Ειδήσεις από την Ελλάδα και τον Κόσμο, τη στιγμή που συμβαίνουν, στο thebest.gr